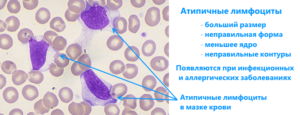
image
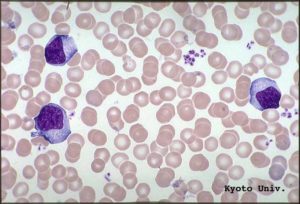
image

Атипичные лимфоциты в крови у ребенка
Слово атипичные не дарит приятных ассоциаций, ведь атипичными называются измененные клетки организма, вызывающие появление рака. Тем не менее, если вам говорят, что у вас в крови повышены атипичные лимфоциты.
не стоит бить тревогу и писать завещание. В этом случае атипичные значит необычные , то есть имеющие не свойственные лимфоцитам особенности.
С онкологией они не имеют ничего общего и встречаются при совершенно других болезнях.
Что такое атипичные лимфоциты и как они выглядят:
Как известно, при раздражении антигенами, а также во время некоторых заболеваний (вирусные болезни, аллергии) показатели лимфоцитов повышаются. Наряду с этим некоторые из них меняют свои свойства и внешний вид.
Атипичные лимфоциты приобретают следующие особенности
Они становятся крупными. Обычно макрофаги – самые большие лейкоциты, а лимфоциты редко вырастают более чем до 12 мкм. Когда они становятся атипичными, их размер может составлять 30 мкм и более.
Нормальный лимфоцит имеет форму, близкую к округлой. Измененные же формы клеток приобретают неправильную, многоугольную форму, а их границы могут выглядеть рваными .
Если мазок крови, в котором изучают показатели лимфоцитов, окрасить стандартными красителями (для этого используют гематоксилин и эозин), то атипичные клеточки будут приобретать более яркую окраску, чем нормальные .
Ядро их фиолетовое, а цитоплазма серая, темно-синяя либо голубая.Если атипичные лимфоциты появились у пациента, зараженного цитомегаловирусом или вирусом Эпштейна-Барра, то их называют клетками Дауни.
Дело в том, что в 1923 году американский врач-гематолог с такой фамилией одним из первых увидел их в микроскоп и описал их свойства.Некоторые лимфоциты с атипичными свойствами также называют клетками Ридера, или амитотическими лимфоцитами.
Их особенность состоит в том, что у них почкообразная форма и ядра с зазубренными контурами или перетяжкой посередине, разделяющей их на дольки.
Также среди атипичных лимфоцитов выделяют клетки Боткина-Клейна-Гумпрехта. Сразу три ученых описали специфические клетки, которые встречаются при лимфаденозах. Собственно, это не живые клетки, а их останки, которые какие-то время циркулируют в крови. За то, что их едва видно, эти лимфоциты еще называют клетками-тенями.
Где находятся атипичные лимфоциты:
Обнаруживают их главным образом в крови, так как именно кровь берут на анализ, чтобы изучить эритроциты, лейкоциты, лимфоциты и прочие важные показатели. Но в тканях их тоже немало.
В организме взрослого человека может быть 6% атипичных лимфоцитов, даже если этот человек полностью здоров. Когда же в связи с болезнью у пациента наблюдаются высокие лимфоциты в крови. то показатель атипичных может подниматься до 7-10% и выше.
Чем обусловлено появление атипичных лимфоцитов?
Когда человек болеет, и его организм нуждается в защите, иммунная система должна выработать достаточное количество лимфоцитов, чтобы они общими усилиями смогли справиться с агрессором. Увы, иногда ресурсов иммунитета на это не хватает.
Клетки вырабатываются, однако не могут полноценно созреть и подготовиться к встрече с возбудителем или аллергеном. Так и получается, что в крови возрастает количество таких необычных лимфоцитов.
Они выполняют нужные функции, но вот внешность у них не очень полноценна.
Иногда высокие лимфоциты в крови и появление атипичных форм наблюдаются не только при ОРВИ и аллергиях. но и в более серьезных ситуациях. К появлению их большого количества могут приводить коклюш, сифилис, туберкулез. лимфолейкоз, бруцеллез, токсоплазмоз, сывороточная болезнь.
Что делать, если в крови повышены атипичные лимфоциты?
Вариант только один: лечиться, принимая терапию, прописанную доктором. Это, в зависимости от природы заболевания, могут быть самые разные медикаменты и методики. Кроме того, по согласованию с лечащим врачом можно принимать препарат Трансфер Фактор .
Присутствие атипичных лимфоцитов указывает на то, что иммунная система человека работает в напряженном режиме. Это средство позволяет ей помочь.
Оно создано на основе информационных молекул, извлеченных из коровьего молозива и яичных желтков. Молекулы обучают лимфоциты правильной работе, что ускоряет их образование, созревание и повышает работоспособность.
Регулярный прием препарата помогает быстрее восстановить здоровье и вернуть нормальные показатели крови.
Атипичные лимфоциты
Атипичные или реактивные лимфоциты — это крупные лимфоциты, появляющиеся в результате антигенной стимуляции при инфекционных или аллергических заболеваниях. Атипичные лимфоциты в размере превышают 30 мкм, имеют неправильную форму.
Ядро атипичного лимфоцита может быть круглым, эллиптическим, с зазубренными контурами, расщелинами. Цитоплазмы больше чем в типичном лимфоците, выраженная базофилия (при окраске имеет насыщенно голубой цвет). Иногда присутствуют гранулы азурофильной зернистости, вакуоли. Чаще цитоплазма серого, голубого или темно-синего цвета.
Атипичные лимфоциты появляющиеся при цитомегаловирусной и эпштейн-барр вирусной инфекции называют клетками Дауни, по имени американского гематолога, описавшего их в 1923 году.
Реактивные лифоциты появляются в кровотоке в случае резкой необходимости в лимфоцитах. В таком случае лимфоциты просто не успевают «созреть» и приобрести полноценную морфологию. При стихании инфекционного процесс количество атипичных лимфоцитов резко снижается до нормы
Причины появления атипичных лимфоцитов в крови:
- Лимфолейкоз.
- Вирусная инфекция — инфекционный лимфоцитоз, инфекционный мононуклеоз, инфекционный гепатит, вирусная пневмония. экзантема в детском возрасте, паротит, ветрянка, цитомегаловирусная и эпштейн-барр вирусная инфекция.
- Коклюш .
- Бруцеллез.
- Сифилис (на некоторых стадиях).
- Токсоплазмоз.
- Реакции на лекарства и сывороточная болезнь.
У здоровых людей может быть до 6% атипичных лимфоцитов в анализе крови .
Папилломы — ПРИЗНАК наличия паразитов в теле! На ночь нужно пить кружку.
Наталья уже как щепка (-25 КГ за месяц)! Для этого она дважды в день.
Лимфоциты в крови: что значит превышение нормы у ребенка и взрослого
Лимфоциты в крови?
Получая на руки результаты сданных анализов крови или мочи, большинство обывателей с растерянностью читают непонятные обозначения, проценты и определение граничных показателей.
А видя диковинные подписи, паникуют, считая, что им поставили неизлечимый диагноз.
На самом деле, все не так печально: это специалисты лаборатории расшифровали лимфоциты в крови, указывая на возможные отклонения от нормы медицинскими терминами. Что означают эти показатели? Норма лимфоцитов в крови
Лимфоциты являются представителями белых кровяных телец, иначе – лейкоцитов (WBC).
Они первыми определяют «чужака», распознают инородные антигены, вырабатывая механизм адекватного ответа на проникновение инфекций, вирусов.
Лимфоциты подразделяются на: В-клетки. Сталкиваясь с антигенами, В-лимфоциты производят антитела против конкретного вида проникших инородных структур. Периферическая кровь содержит от 8 до 20%. Т-клетки (цитотоксические лимфоциты) составляют до 70%. NK (Natural Killers) – клетки-убийцы чужеродных тел.
Их число в крови невелико – от 5 до 10%. Атипичные лимфоциты, которые представлены: О-лимфоцитами (нулевыми клетками), не имеющими характерных для вышеуказанных клеток рецепторов. К-, Ь-, ЕК-лимфоцитами, которые действуют нестандартно: изменяют свойства, завися от антигена.
Где образуются лимфоциты? За воспроизводство этих клеток отвечает красный костный мозг и его лимфатический отдел кроветворения. Распространенное мнение, что лимфоциты «блуждают» по крови, убивая известные только им вирусы – ошибочно.
В периферической крови находится около 2% всего запаса лимфоцитов, остальные содержит лимфоидная ткань, лимфатические узлы.
Уровень лимфоцитов у взрослых в крови составляет от 25 до 40% общего количества белых кровяных телец – лейкоцитов. У женщин и мужчин этот показатель имеет незначительные отличия.
Изменения гормонального фона, вызванные менструацией, при беременности, сказываются на качественных показателях клинического анализа крови: в этот период происходит увеличение удельного веса лимфоцитов до 50 – 55%.
Этот метод генных исследований позволяет выявить точную структуру клеток, разграничивая причины отклонений от нормы на реактивные и опухолевые. Наличие в крови пролимфоцитов, лимфобластов свидетельствует о патологии в организме. Анализ на активированные лимфоциты. Рекомендуется врачом при затяжной болезни вирусного/инфекционного характера для определения течения заболевания, а также оценки эффективности назначенного лечения.
Детский организм до 13 – 15 лет имеет «собственное мнение» о количестве лимфоцитов в крови. Так, у грудничка первые 4 дня жизни превалируют в крови нейтрофилы, а с 5 нормальный уровень лимфоцитарных клеток увеличивается до 40-50%.
С целью защиты от вирусных инфекций, природа сделала так, что у детей в возрасте одного года этот показатель составляет около 60%, постепенно снижаясь к 4 – 6 годам.
В этом возрасте показатели нейтрофилов и лимфоцитов сравниваются, а по достижении 12-ти лет среди лейкоцитов вновь преобладают нейтрофилы.
Повышенное содержание лимфоцитарных клеток в крови называется лимфоцитозом. Важнейшим вопросом при этом является установление причины такой клинической картины.
Превышение нормы может быть вызвано: Реактивным ответом на чужеродные тела. Снижение показателей до нормального состояния происходит в течение месяца-двух после выздоровления. Злокачественными образованиями.
Чтобы исключить данный диагноз, проводятся дополнительные биохимические исследования, анализы.
Лимфоциты повышены у взрослого
Проявляется как: Абсолютный лимфоцитоз – общее количество иммунных стражей организма резко возрастает как ответ на заболевание или патологию.
Относительный лимфоцитоз – изменяется удельный вес лейкоцитов в структуре лейкоцитарной формулы: не меняя абсолютного значения в крови, они «вытесняют» другие клетки, например, нейтрофилы.
Причинами являются: Инфекционные заболевания вирусного типа. Хронические болезни. Аллергический ответ на некоторые виды медицинских препаратов. Перенесенные заболевания, которые требуют времени на восстановление защитных сил организма.
Сдавая кровь на анализ в этот период, будьте готовы встретить «странные» расшифровки на карточках результатов: плазматизация цитоплазмы лимфоцитов – означает изменение структуры клетки, приближая ее по свойствам к моноцитам; лимфоцитоз гранулопения при беременности показывает наличие воспалительных инфекций у будущей мамочки. Эндокринные сбои организма. Лейкозы и лимфолейкозы.
Причины появления у детей
Высокие лимфоциты у деток в крови вызваны зачастую вирусными заболеваниями, которые помогают вырабатывать пожизненный иммунитет к кори, краснухе, паротиту, ветрянке и пр.
Абсолютное повышение иммунных клеток порой сигнализирует о начинающемся ОРВИ или гриппе. Когда лимфоциты и моноциты повышены, особое внимание следует обратить на вероятность такого заболевания, как мононуклеоз.
Если длительное время после выздоровления этих клеток все еще много в крови, необходимо обратиться к гематологу или онкологу.
Например, нейтрофилов при пневмониях, гнойных инфекциях становится больше, а лимфоциты падают.
Абсолютная лимфопения характерна при заболеваниях, когда костный мозг не может продуцировать иммунные тела или производит незрелые клетки.
Низкие лимфоциты у взрослых.
Наличие лимфоцитов в крови ниже нормы не вызывает тревоги, если этот показатель связан с вирусной инфекцией (ОРВИ) в самом разгаре. Организм усиленно подавляет инородные тела за счет воздействия имеющихся иммунных клеток, а новые еще не сформированы.
Аналогичный механизм наблюдается у лиц, страдающих ВИЧ-инфекцией, когда истощенный организм не успевает восполнять запасы лейкоцитов.
При нарушениях деятельности органов, отвечающих за производство/созревание лимфоцитарных клеток, наблюдается стойкое, длительное снижение от нормы:
при беременности; анемии; при лечении кортикостероидами; болезни Иценко – Кушинга; при онкологии или после проведенной химиолучевой терапии.
Источники: http://www.transferfaktory.ru/atipichnyie-limfotsityi, http://pro-analizy.ru/atipichnye-limfocity/, http://ebolanews.ru/2015/11/limfocity_v_krovi_chto_znachit_prevyshenie_normy_u_rebenka_i_vzroslogo_427027.html
Комментариев пока нет!
Источник: http://orebenkah.ru/krov-u-detej/atipichnye-limfocity-v-krovi-u-rebenka.html
Атипичные лимфоциты в анализе крови у взрослых и у ребенка
Атипичные лимфоциты могут возникать при некоторых заболеваниях. Многие считают, что их появление свидетельствует о наличии рака, но это не так. Такие лимфоциты свидетельствуют о наличии аллергии или инфекции.
Лимфоциты — это разновидность лейкоцитов, которые отвечают за защиту органов от патогенных микроорганизмов. Они способствуют уничтожению и выведению из организма бактерий. Под воздействием некоторых из них лимфоциты меняют свои свойства и размер.
Такое состояние не является нормальным и требует дополнительных исследований для выяснения причины проблемы и ее устранения.
Особенности атипичных лимфоцитов
Если в организме начинается патологический процесс, то уровень лимфоцитов возрастает. Такое состояние называют лимфоцитозом. Оно требует дополнительных обследований.
Лимфоцитоз может быть трех видов:
- реактивный. Он развивается, если защитные силы организма ослабевают. Тогда появляется большое количество атипичных клеток, которые обладают неполноценными свойствами;
- постинфекционный. Он возникает, когда человек вылечился от вирусной или инфекционной болезни;
- злокачественный. Это состояние возникает у людей, которые страдают онкологическими заболеваниями. При этом также вырабатывается большое количество атипичных белых кровяных телец.
Атипичные лимфоциты, появившиеся под воздействием антигенов, обретают такие характерные признаки:
- Меняется их размер. В обычном состоянии самые большие лейкоциты — макрофаги достигают в размере не более двенадцати микрометров. Лимфоциты очень редко имеют большие размеры, но под воздействием вирусов они могут вырастать до тридцати микрометров. Именно такими являются атипичные лейкоциты.
- В нормальном состоянии лимфоцит круглой формы. Когда структура клеток меняется, они могут становиться многоугольными с рваными гранями.
- Подвергаются изменениям и ядра лимфоцитов. В анализе крови можно обнаружить, что у атипичного лейкоцита ядро удлиняется и покрывается расщелинами, тогда как в обычном состоянии имеет круглую форму, удлиненную совсем незначительно.
- Меняется и цвет лейкоцитов. Так, процедура анализа крови включает определение окраса клеток крови. Для этого во взятый у пациента биоматериал добавляют гематоксилин и эозин. Это стандартные красители. Во время этой процедуры можно увидеть, что реактивные или атипичные лейкоциты имеют более яркий окрас, чем обычные. Они обретают темно-серый или синий цвет с фиолетовым ядром.
Существует несколько видов реактивных лейкоцитов.
Их назвали по именам ученых, которые их впервые обнаружили и описали:
- клетки Дауни. Их открыли в 1923 году. Ученый обнаружил эти клетки у больных, зараженных цитомегаловирусом или вирусом Эпштейна-Барра;
- клетки Ридера или амитотические лимфоциты. Они отличаются от других тем, что их ядро разделено пополам и имеет зазубренные контуры, а сама клетка почкообразной формы;
- клетка Боткина-Клейна-Гумпрехта. Над их описанием работали сразу трое ученых. Подобные лейкоциты обнаруживаются при лимфаденозе. Это мертвые клетки, которые некоторое время находятся в крови. Обнаружить их очень трудно, поэтому их еще называют тенями.
Почему они появляются
Наличие атипичных лимфоцитов чаще всего обнаруживают в крови у ребенка или взрослого при общем анализе крови, когда исследуют ее на уровень эритроцитов, лейкоцитов и тромбоцитов. Но они могут попадать также и в ткани.
У взрослого человека могут в крови обнаружить некоторое количество атипичных лейкоцитов даже при отсутствии заболеваний. Когда в организме начинает развиваться какая-то болезнь, уровень лимфоцитов возрастает, увеличивается количество и атипичных лейкоцитов.
Главные причины возникновения неправильных лейкоцитов — это вирусы и аллергии.
Когда возбудитель болезни попадает в организм, то иммунитет начинает вырабатывать больше лимфоцитов, чтобы они могли справиться с проблемой.
Когда человек начинает выздоравливать ситуация улучшается и количество неправильных лимфоцитов уменьшается.
Атипичные лимфоциты могут развиваться под воздействием:
- Лимфолейкоза — это онкологическое заболевание, которое заключается в поражении злокачественными клетками лимфатической ткани.
- Бруцеллеза — это инфекция, которой страдают домашние животные. К человеку она попадает через продукты животного происхождения и поражает нервную и сердечно-сосудистую системы, а также кости и суставы.
- Некоторых стадий сифилиса — венерической инфекции, которая характеризуется поражением кожи, слизистых оболочек, внутренних органов, костей и нервной системы.
- Токсоплазмоза — инфекции, которая обычно протекает бессимптомно и вызывается токсоплазмами. Переносят инфекцию обычно кошки.
- Вирусных инфекций, например, пневмонии, ветрянки, которой чаще всего болеют дети, гепатита и других.
- Некоторых лекарственных препаратов, а также во время лечения иммунными сыворотками животного происхождения.
У детей атипичные лимфоциты и лимфоцитоз могут возникнуть при таких проблемах, как коклюш, полиомиелит, корь, малярия, при гриппе, ангине, острых респираторных инфекциях, менингите, воспалениях, которые сопровождаются выделением гноя, при онкологических заболеваниях.
Поэтому очень важно выявить проблему и ее причину на ранних этапах развития. Это значительно ускорит выздоровление и позволит избежать серьезных последствий для внутренних органов.
Что делать, если обнаружили лимфоциты реактивные
При обнаружении в крови атипичных лейкоцитов необходимо пройти дополнительные исследования, чтобы обнаружить причину возникновения этого явления. Только узнав, что вызвало отклонения, можно подобрать правильную терапию и вылечить пациента.
Могут использовать самые разнообразные методики и препараты.
Наличие в организме атипичных лимфоцитов свидетельствует о том, что иммунная система работает в напряженном режиме и ей необходима помощь, поэтому следует начать лечение, так как вирусы, которые вызвали это состояние, могут иметь достаточно серьезные последствия, особенно если заболел ребенок.
Какой-то определенной терапии нет.
Лечение зависит от симптоматики:
- если появились отеки, назначают противоаллергические препараты;
- при бактериальных инфекциях не обойтись без антибиотиков;
- желательно укреплять иммунитет. Для этого врач может назначить витаминно-минеральные комплексы, также необходимо вести здоровый образ жизни, правильно питаться, заниматься спортом.
Наличие атипичных клеток в анализе крови свидетельствует о том, что в организм попал вирус, поэтому при наличии такой проблемы необходимо обязательно выяснить причину изменения состава крови и принять соответствующие меры.
Источник: http://BolezniKrovi.com/sostav/leykocity/atipichnye-limfocity.html
Атипичные лимфоциты: что это такое, и почему появляются?
Основная причина возникновения лимфоцитоза у ребенка – инфекционное заражение.
Кроме того, повышенное содержание лимфоцитов в крови встречается при аутоиммунных, аллергических патологиях и раковых опухолях костного мозга.
Причины увеличения содержания лимфоцитарных клеток:
- бактериальные, вирусные, грибковые инфекционные заболевания;
- реакция на проведенное вакцинирование;
- прием лекарственных препаратов;
- пищевое и химическое отравление;
- болезни щитовидной железы;
- радиационное облучение;
- недостаточность надпочечников;
- дефицит витамина B12;
- чрезмерные физические нагрузки;
- нервное перенапряжение;
- патологии иммунной системы – аллергии и аутоиммунные расстройства;
- онкологические заболевания лимфатической и кроветворной систем.
Дети, длительное время находящиеся в состоянии стресса или пребывающие на солнце, находятся в группе риска возникновения лимфоцитоза.
Количество лимфоцитов в крови у детей разного возраста отличается: у младенцев от рождения до одного года жизни содержится 18 – 70 процентов лимфоцитарных клеток, от года до двенадцати лет – 30 – 45 процентов.
Чем старше становится ребенок, тем концентрация лимфоцитов уменьшается.
При изменении состояния здоровья и подозрении на развивающееся заболевание лечащий педиатры обязательно должен назначить сдачу развернутого анализа крови, результаты которого укажут на возможные изменения соотношения элементов крови.
Следует отметить, что повышение количества лимфоцитов в крови возможно в процессе формирования иммунной системы ребенка до достижения им четырехлетнего возраста.
Такое состояние не считается патологическим и не требует проведения лечения.
Часто лимфоцитоз диагностируется во время проведения периодического медицинского обследования. Поставить точный диагноз и определить причину повышения лимфоцитов в крови может только педиатр. Самолечение может быть опасным для здоровья ребенка.
Чтобы вовремя заметить развивающееся заболевание, родители должны внимательно следить за малышом – за тем, как он играет, ест и спит.
Признаки развития патологического содержания лимфоцитов
У некоторых людей повышение лимфоцитов встречается без развития какого-либо заболевания. В таких случаях специалисты указывают на индивидуальные особенности организма.
В большинстве случаев лимфоциты повышаются после инфекционного заражения. При лимфоцитозе увеличиваются лимфатические узлы, селезенка и печень.
Остальные симптомы лимфоцитоза напрямую зависят от основного заболевания. Признаки могут быть незначительными или практически не проявляться.
Симптомы заболеваний, вызывающих лимфоцитоз:
- увеличение селезенки, лимфоузлов, долей печени;
- очаги воспаления на слизистой поверхности носа и ротовой полости;
- нарушение работы органов пищеварения;
- гипо-и гипертермия;
- слабость и сонливость;
- бессонница;
- головные боли;
- общее снижение активности.
Если у детей результаты проведенного анализа показали повышенное количество лимфоцитов, то для уточнения диагноза «лимфоцитоз» врачом назначается дополнительное обследование:
- определение болезнетворного микроба, вызвавшего патологию;
- изучение состава крови на соотношение клеток иммунной системы;
- выявление аутоиммунных патологий;
- анализ костного мозга – миелограмма;
- иммунофенотипирование.
Если у ребенка увеличена селезенка, лимфоузлы и печень, то ему назначают рентгенологическое и ультразвуковое исследование, магнитно-резонансную томографию, цитологический анализ содержимого лимфоузлов и определение содержания онкомаркеров.
:
Одним из новейших методов диагностирования лимфоцитоза на раннем этапе считается молекулярно-генетический метод реаранжировки генов.
Внешние проявления лимфоцитоза схожи с симптомами нескольких патологий. Диагностировать заболевание может только специалист в условиях стационара, так как для обследования необходимо сложное оборудование.
Какие показатели считать повышенными?
Лимфоцит формируется из стволовой клетки, когда это необходимо организму. Существует несколько их видов: B, T, Nk.
Лимфоциты группы B способны вырабатывать иммуноглобулины – особые клетки, наличие которых объясняет иммунитет к вирусным и инфекционным заражениям.
Т-лимфоциты способны ликвидировать чужеродные патогенные клетки, которые уже проникли в клетки организма, вступая с ними в контр-реакцию.
Лимфоциты последней группы помогают контролировать процесс отмирания и деления клеток, поскольку способны противостоять формированию раковых опухолей.
Когда речь заходит о высоких значениях, то нужно знать, что в данном случае является нормой. Для мужчин и женщин показатели идентичные, разница в количестве только из-за возрастных качеств:
- новорожденные – 15-35%;
- дети до 1,5 лет – 45-65%;
- дети до 12 лет – 40-55%;
- подростки 12-16 лет – 40-50%;
- от 16 до 35 лет – 35-45%;
- старше 35 лет – 30-40%.
Данные показатели являются относительными, то есть учитывается их процентное соотношение к общему объему крови.
Обычно в анализе крови используются именно эти данные, отображающие количественный состав белых клеток. В случае, когда есть необходимость уточнения, используют абсолютные значения, отображающие абсолютное содержание иммунных клеток в 1 литре крови, которые также отличаются по возрастам:
- дети до 6 лет – 0,8-9*109 клеток на литр крови;
- 6-16 лет — 0,8-8*109 клеток на литр крови;
- старше 16 – 0,8-4*109 клеток на литр крови.
Повышение лимфоцитов отмечается тогда, когда полученные показатели близки к верхней границе (немного повышены), или превышают это показатель.
Степень превышения рекомендованных стандартов указывает на опасность состояния для здоровья человека.
Каким анализом определяется?
Для определения количественного и качественного состава лимфоцитов используют общий анализ крови, забор которой осуществляют из пальца. Далее кровь рассматривается под микроскопом, где видны все ее фракции. Выделенные лимфоциты подсчитываются, при этом учитывается степень их зрелости, объемы и другие индивидуальные показатели.
Манипуляция может осуществляться как вручную с использованием микроскопа, так и с помощью современных аппаратов, способных автоматизировать данный процесс.
Что может повлиять на результаты анализа?
В медицинской практике нет определенных факторов, которые могут кардинально изменить картину, если повышены лимфоциты. Однако незначительные колебания могут быть спровоцированы соблюдением строгой диеты, сильными физическими нагрузками, а также постоянными стрессами. Поэтому перед сдачей анализа желательно хорошо выспаться и отдохнуть.
Симптомы и признаки
Ранние стадии патологии, когда количество лимфоцитов в крови повышено незначительно, практически не имеет внешних клинических проявлений. Человек ощущает слабость, а также снижение выносливости. По мере увеличения численности лимфоцитарных клеток могут проявляться такие симптомы, как:
- Увеличение лимфоузлов в области шеи и в подмышечных впадинах.
- Кашель без видимых причин, насморк и боль в горле, что схоже с проявлением простуды.
- Сильные головные боли, которые не могут самоустраняться.
- Увеличение температуры тела, появление озноба и холодного пота.
- Проблемы с пищеварительным трактом: запоры и поносы, рвоты, отсутствие аппетита.
- Мышечные боли в области спины.
- Бессонница и истощение организма.
Источник: https://zdorovo.live/serdtse-i-sosudy/atipichnye-limfotsity-chto-eto-takoe-i-pochemu-poyavlyayutsya.html
Общие сведения и интересные факты о лимфоцитах
Не секрет, что за борьбу с болезнями в нашем организме отвечают крохотные тельца, называемые антителами. За их выработку отвечает красный костный мозг — орган кроветворения, в недрах которого созревают новенькие иммунные клетки: лимфоциты, нейтрофилы, базофилы, эозинофилы и моноциты.
Главнейшим агентом иммунного ответа являются лимфоциты — их численность в крови преобладает над всеми остальными, именно с помощью них организм ведёт основную борьбу с инфекцией. Большинство лимфоцитов имеет правильную круглую форму и чёткие контуры, однако есть клетки, параметры которых немного отличаются от «оригинала». Такие клетки учёные называют атипичными.
Атипичные или реактивные лимфоциты — это особые иммунные тела, появляющиеся при аллергических реакциях, инфекционных и других заболеваниях. Неправильная форма и размер клеток обусловлены воздействием патогенных микроорганизмов, полностью меняющих их структуру. В норме атипичные иммунные тела не должны появляться вообще, а их наличие может указывать на развитие различных заболеваний.
В этой статье мы расскажем вам, что делать, если в вашем анализе крови обнаружены атипичные лимфоциты, поведаем о причинах, которые могли спровоцировать их рост.
В чём проявляется атипичность лимфоцитов?
Как известно, лимфоциты участвуют в процессах иммунного ответа — то есть, одни из первых бросаются на борьбу с опасными микроорганизмами. В результате этой борьбы они могут приобретать следующие параметры:
Обычно лимфоцит имеет круглую форму и ровные границы. Атипичные лимфоциты отличаются рваными контурами и неправильной многоугольной структурой.
В нормальном состоянии размер лимфоцита не превышает 12 мкм. Увеличение этого показателя говорит о его атипичности.
Атипичные лимфоциты также имеют более яркий окрас, при добавлении в анализируемую кровь красителя гематоксилина — это также один из способов выявления необычных клеток.
А вы знали, что черты характера человека влияют на его уровень сопротивляемости болезням? Есть исследование, подтверждающее, что активные и уверенные в себе люди вырабатывают большее количество клеток иммунного ответа, что и помогает им бороться с болезнями. Таким образом, оптимистичный и положительно настроенный человек имеет меньше поводов для беспокойства о своём здоровье.
Причины появления атипичных лимфоцитов
Многие люди, напуганные различными статьями в интернете и медицинских справочниках, уже на рефлекторном уровне начинают паниковать при виде слов «атипичный», «неправильный» и «мутагенный», ассоциируя их с онкологическими заболеваниями. Не спорю, повышенное число лимфоцитов, как и появление атипичных лимфоцитов, может являться косвенным симптомом рака, но это лишь одна из возможных причин, причём не самая распространённая.
Гораздо чаще к усилению выработки лимфоцитов приводит какая-либо инфекция или же аллергическая реакция. Такое явление называют лимфоцитозом. Медики различают три разновидности данного заболевания: реактивный, постинфекционный и злокачественный. Первые два связаны с ослаблением функций организма в результате инфекции, третий — с наличием опухолевого процесса в организме.
Лимфоцитоз неизбежно ведёт к образованию неправильных лимфоцитов, а точнее, он является одним из факторов, сопутствующих данной патологии. Причин у неё может быть несколько:
- Приём определённого круга лекарственных препаратов (к примеру, иммунных сывороток органического происхождения);
- Инфекционные заболевания: пневмония, ветрянка, гепатит и т.д.
- Бруцеллёз — заболевание, поражающее домашних животных. Попадая в организм человека через продукты питания, может вызывать нарушение в работе различных систем, в том числе и иммунной;
- Токсоплазмоз — заболевание без явной клинической картины, поражающее, однако, иммунные клетки организма и приводящее к возникновению реактивных лимфоцитов;
- Лимфолейкоз — злокачественное поражение лимфатических узлов, характеризующееся накоплением в них раковых клеток;
- Коклюш — заболевание дыхательных путей, сопровождаемое судорожным кашлем. Чаще всего встречается у детей;
- Сывороточная болезнь — аллергия на препараты животного происхождения;
- Сифилис на некоторых стадиях.
Уровень агранулоцитов в крови определяется общим анализом крови (на тромбоциты, эритроциты и лейкоциты). Сдаётся такой анализ обычно с утра и на голодный желудок.
Стоит отметить, что в крови взрослого человека можно обнаружить атипичные лимфоциты и при отсутствии патологического процесса в организме, поэтому так важно проконсультироваться с врачом насчёт результатов вашего анализа — именно он первым заметит неладное и посоветует, что делать в сложившейся ситуации.
Ещё одним немаловажным фактором развития атипичных агранулоцитов является аллергия. Врачи по всему миру твердят о том, что аллергические реакции станут одной из главных проблем, преследующих городских жителей в XXI веке.
Дело в том, что в условиях экологических катаклизмов и загрязнённости воздуха, иммунная система человека начинает работать неправильно, «сбоить».
Официальная статистика показывает, что уже сейчас число болеющих аллергией детей составляет 15%!
Норма атипичных лимфоцитов и лечение
В организме здорового человека может содержаться до 6 % атипичных лимфоцитов, большая часть из них консолидируется в кровеносной системе. Стоит встревожиться, если этот уровень превышает 7-10%, именно на это и необходимо указать своему врачу.
Лечение атипичных лимфоцитов, естественно, заключается в выявлении первопричины, а до тех пор не стоит прибегать к каким-то серьёзным мерам.
Чаще всего врачи назначают:
- Витаминно-минеральную терапию, укрепляющую иммунитет.
- Если заболевание имеет вирусную природу, соответственно назначаются антибиотики и противовирусные препараты.
- Антигистаминные и противоаллергические лекарства, если образование атипичных лимфоцитов спровоцировано аллергией.
Не стоит забывать также и о правильном питании, здоровом образе жизни и других мероприятиях, направленных на укрепление организма.
Лимфоциты — это группа иммунных клеток крови, подвид лейкоцитов, участвующая в борьбе организма с инородными телами и вирусами.
Когда иммунная клетка сталкивается с серьёзной проблемой, его структура, размер и цвет могут меняться, и тогда можно говорить о развитии его атипичности.
На этом всё, следите за состоянием своего организма, ведите здоровый образ жизни и не пускайте на самотёк имеющиеся проблемы, именно в этом и заключается секрет крепкого здоровья. Удачи!
Источник: http://medprevention.ru/limfouzly/limfoma-i-limfadenit/3650-obshchie-svedeniya-i-interesnye-fakty-o-limfotsitakh
Лимфоцитоз у детей: относительный и абсолютный, норма и причины повышения уровня
Детский организм постоянно подвергается воздействию окружающей среды и такое воздействие бывает негативным в виде инфекций или заболеваний. Иммунная система здорового ребёнка способна беспрепятственно противостоять таким болезням. Происходит это методом увеличения или снижения компонентов в крови. К таким компонентам относятся лейкоциты.
Именно они борются с чужеродными клетками, попавшими в организм. Во время развития заболевания количество лейкоцитов увеличивается, что позволяет быстро и качественно побороть инфекцию в организме. Лимфоцитоз – превышенное содержание лимфоцитов в крови выше определенного уровня.
Различают 2 вида лимфоцитоза:
- Абсолютный;
- Относительный.
Абсолютный лимфоцитоз говорит о том, что на литр крови количество лимфоцитов превышено. Сопровождается:
Увеличение лейкоцитов в крови – признак инфекционных заболеваний
- вирусными поражениями;
- коклюшом;
- вирусом гепатита;
- инфекционным мононуклеозом;
- туберкулёзом;
- нарушением работы щитовидной железы;
- наличием в организме злокачественной опухоли;
- поражением токсоплазмой.
Относительный лимфоцитоз говорит об неизменном количестве телец в крови. Такой вид патологии в практике встречается намного чаще.
Отклонение такого вида указывает на то, что пациент находится в стадии выздоровления или о недавнем наличии инфекционного заболевания.
При обнаружении превышенного количества тел в анализах стоит вспомнить недавно-перенесённые болезни или обратить внимание на наличие симптомов начинающегося заболевания.
Относительное увеличение тел в крови является нормой лишь у детей возрастом до 2 лет. Нормой у подростка считается показатель не выше 37%.
Причины повышенного уровня лимфоцитов
Спровоцировать повышение уровня кровяных тел может длительная физическая нагрузки или же эмоциональные стрессы.
Если количество лимфоцитов в крови достигло предельного уровня, то это указывает на серьёзные взрослые заболевания, такие как:
- инфекционный мононуклеоз;
- туберкулёз;
- саркома;
- цитомегаловирус.
Также к причинам развития лимфоцитоза можно отнести вирусные заболевания или патологические процессы, происходящие в организме.
Существует ряд причин лимфоцитоза у детей, к ним относятся:
- переливание крови;
- авитаминоз;
- ВИЧ-инфекция;
- приём определённых лекарственных препаратов;
- длительное пребывание на солнце;
- плохое питание.
У большинства детей после выздоровления, в течение нескольких месяцев, лимфоциты могут оставаться повышенными. Не стоит переживать по этому поводу, потому что это нормальное явление. Их уровень будет постепенно снижаться до нормального уровня.
Как распознать болезнь у ребёнка
Явных признаков у лимфоцитоза нет. В основном болезнь диагностируется, когда человек сдаёт назначенный педиатром анализ крови. Исключением являются инфекционные заболевания, так как они имеют свой перечень признаков. К ним относится слабость, вялость, сыпь, кашель, боль в горле, насморк, повышенная температура тела, озноб.
Если развивается абсолютный лимфоцитоз, то это вероятный признак опухоли ткани. В таком случае больной будет ощущать боли в костях, постоянную лихорадку. Увеличивается в размерах печень и селезёнка. Организм чаще подвергается инфекционным заболеваниям из-за сниженного иммунитета на фоне поражения организма вирусом.
Мультфильм о работе клеток иммунной системы – лимфоцитах и их роли в развитии онкологии. Информация дана в доступном виде для понимания даже детьми.
Отличием детской и взрослой нормы лимфоцитов является количество кровяных телец. У детей в возрасте до 10 лет незначительное повышенное количество лимфоцитов является нормой. В то время, как у взрослого это уже будет считаться признаком для беспокойства.
Средняя норма телец в крови у малыша составляет от 40 до 70%. Поэтому, если взрослый увидел высокий показатель в анализах ребёнка, он не должен делать самостоятельные выводы, а стоит проконсультироваться с педиатром. В большинстве случаев причин для паники нет.
Симптомы детского лимфоцитоза
Если болезнь возникла вследствие вирусного заболевания, то у малыша появляются такие симптомы, как слабость, лихорадка, беспокойный сон, отсутствие аппетита, появление сыпи. Из-за повышенной нагрузки на печень, селезёнку и лимфоузлы они увеличиваются в размере.
Один из симптомов лимфоцитоза – увеличение лимфоузлов. Нормальный размер – не более 1 см
Важным признаком проявления болезни является то, что температура тела может подниматься до критических показателей, при этом жаропонижающие средства не будут помогать.
Помимо лимфоцитов в состав крови входят нейтрофилы. Эта группа клеток направлена на борьбу с вирусными инфекциями. Нейтропения и лимфоцитоз могут встречаться одновременно.
Методы диагностики
Чтобы диагностировать снижение кровяных телец пациенту не нужно проходить разные обследования и сдавать многочисленные анализы. Но и внешне поставить такой диагноз не получится. Для этого нужно сдать анализ крови. С этими данными врач способен выявить отклонения.
Повышение белых тел в крови малыша в сочетании с другими симптомами говорит о наличии заболевания. Проводится общий анализ или биохимический анализ крови для выявления болезни.
Существуют более детальные методы обследования. Они включают в себя:
- исследование костного мозга;
- исследование иммунной системы;
- выявление вида инфекции.
При необходимости лимфоцитоз можно диагностировать с помощью дополнительных процедур:
- УЗИ;
- рентген грудной клетки;
- компьютерная томография.
Для исключения подозрения раковой опухоли пациент проходит иммунофенотипирование. Если у пациента наблюдается увеличение определённых органов, то к лечению подключаются онкологи.
5 правил для подготовки перед сдачей анализов
Для того, чтобы получить корректный анализ и поставить верный диагноз важно правильно подготовиться к их сдаче.
Чтобы выявить уровень лимфоцитов берут анализ крови. Перед сдачей крови следует соблюдать следующие 5 правил:
- Не употреблять пищу за 12 часов до процедуры. (По этой причине назначают сдачу на утреннее время; кроме грудничков, у них берут анализ крови через пару часов после кормления);
- Пить простую воду можно не позднее чем за 2 часа до процедуры. (Разные сладкие напитки пить запрещается);
- Взрослым не употреблять алкоголь и тяжёлую пищу за сутки до процедуры. Курить перед процедурой запрещено;
- При приёме лекарственных препаратов сообщить об этом врачу перед сдачей крови;
- Желательно сдавать анализы, и проходить лечение в одной и той же больнице.
Норма лимфоцитов в крови
В качестве дополнительной информации представляем таблицу уровня лимфоцитов в крови у здоровых детей:
| 5 суток | 30-50 |
| 10 суток | 40-60 |
| 1 месяц | 45-60 |
| 1 год | 45-65 |
| 5 лет | 35-55 |
| 10 лет | 30-45 |
| 15 лет | 30-45 |
Лечение: к какому врачу обращаться
Первоначально малыша осматривает педиатр. После обнаружения повышенного уровня лимфоцитов в крови и исключения недавних вирусных заболеваний врач направляет ребёнка к гематологу. В целях постановления верного диагноза могут быть назначены дополнительные исследования.
Если уровень лимфоцитов не нормализовался в течение пары месяцев после перенесённого заболевания и наблюдается увеличение лимфатических узлов, печени и селезёнки, то даётся направление к онкологу. Не стоит сразу поддаваться панике, так как в основном направляют на необходимую консультацию.
Лечение лимфоцитоза не проводится, т.к. повышенный уровень лимфоццитов является показателем других заболеваний. Если повышенный уровень лейкоцитов связан с инфекционным заболеванием, то лечат непосредственно его.
Для лечения инфекции используются противовирусные препараты, противовоспалительные или антибактериальные лекарства. Если болезнь осложняется и появляются бактериальные инфекции, то назначаются антибиотики.
После успешного выздоровления лимфоциты приходят в норму спустя некоторое время. Рекомендуется обеспечить малышу достаточный отдых, правильное сбалансированное питание, прогулки на свежем воздухе. Как организовать первые прогулки для новорожденного зимой рассказывается в этой статье.
В случае, если отклонение оказалось более плачевным, то используется химиотерапия. В худших случаях возможна пересадка костного мозга. Ребёнку обеспечивается постельный режим и минимизируется контакт с другими людьми.
Во время лечения могут прописать витаминотерапию, антиаллергенные препараты и обязательный постельный режим.
Жизнь после болезни
К последствиям заболевания относят, во-первых, осложнения при инфекционных болезнях. Во-вторых, запустить распространение доброкачественной или злокачественной опухоли, что приведёт к более серьёзным осложнениям.
После возвращения уровня лимфоцитов в норму пациент не чувствует никаких недомоганий, учитывая, что причиной недуга была вирусная инфекция.
После лечения нет особых противопоказаний и ребёнок продолжает жить активной жизнью. Единственным моментом остаётся то, что родителям стоит задуматься об укреплении иммунитета своего малыша, чтобы исключить появление вирусных заболеваний.
Профилактика
Причина сбоя уровня лимфоцитов кроется в иммунной системе ребёнка. Чтобы обезопасить малыша от возвращения заболевания, важно исключить некоторые моменты из жизни малыша:
- частые стрессы;
- неправильное питание;
- сильные физические нагрузки;
- отсутствие проулок на свежем воздухе;
- инфицирование молодого организма;
- долгое нахождение под жарким солнцем.
Не стоит забывать о профилактических приёмах врачей. Даже если отсутствуют симптомы, лучше предотвратить развитие заболевания на стадии его зарождения.
Выводы
Главным правилом предотвращения заболеваний является своевременный уход. В случае, если какие-то симптомы уже проявились, следует сразу обращаться к врачу и не заниматься самолечением. Это приводит к потере драгоценного времени и усугублению ситуации.
Как прочесть клинический анализ крови, как определить норму содержания лейкоцитов в крови? Об этом расскажет доктор Комаровский.
Источник: https://ipupsik.com/detskoe-zdorove/detskie-bolezni/limfotsitoz-u-detej.html
Поделиться: